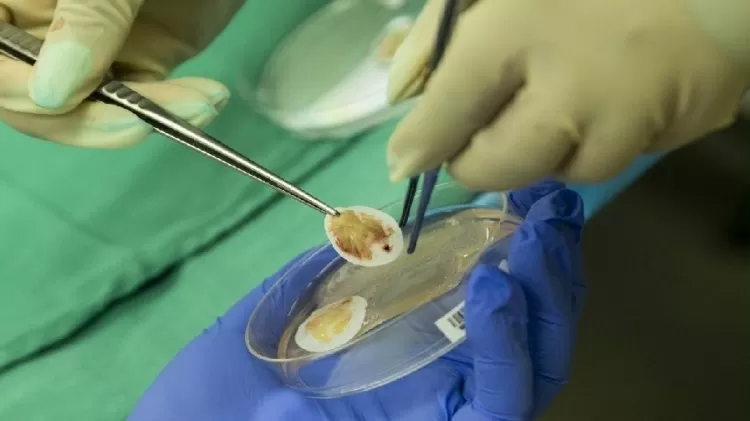

Transplante inédito de coração e timo consegue salvar vida de bebê nos EUA
Um bebê chamado Easton recebeu o transplante do coração e timo ao mesmo tempo. Um feito inédito que pode abrir muitas portas na ciência.
A ciência não cansa de nos surpreender. Frequentemente, recebemos a notícia de um tratamento inovador, um novo medicamento, uma inovação que salva vidas.
E o tema do texto de hoje é sobre o primeiro transplante duplo – sim, transplante de dois órgãos ao mesmo tempo! O protagonista é o bebê Easton Sinnamon, que recebeu coração e timo novos.
O caso aconteceu em 2021, nos Estados Unidos, mas só veio à tona agora. O paciente tinha apenas 6 meses quando tudo aconteceu. Por ter nascido com problemas cardíacos e imunológicos, seu estado de saúde não era dos melhores e ele não podia sair do hospital.
Foram feitas, segundo o site UOL, várias operações cardíacas e tratamentos para infecções frequentes que o corpo do pequeno Easton era incapaz de combater. Vendo a gravidade da situação, os médicos decidiram fazer o transplante duplo de coração e timo (órgão relacionado ao bom funcionamento do sistema imunológico).

Easton Sinnamon ainda não sabe disso, mas fez história ao receber o primeiro transplante duplo (imagem: Duke University/UOL)
“Foi uma daquelas coisas que poderiam ajudá-lo e, se funcionasse não apenas o ajudaria, mas também pode ajudar milhares de outras pessoas com seus filhos que precisam de transplantes“, disse Kaitlyn Sinnamon, mãe de Easton.
Interessante ver aqui como ela enxergava que não se tratava apenas de seu filho. Mas sim de uma inovação capaz de ajudar inúmeras pessoas na fila do transplante. E, para alegria da família e de toda a equipe médica, a operação foi bem-sucedida!
Importante avanço
Seis meses após o transplante, os exames mostram que o coração e o timo do pequeno Easton estão funcionando bem.
“Com essa abordagem bem-sucedida, isso significaria que os receptores de transplante não rejeitariam o órgão doado e também não precisariam se submeter a tratamento com medicamentos de imunossupressão de longo prazo, que podem ser altamente tóxicos, principalmente para os rins”, comemorou Joseph Turek, médico do bebê.
Tecido do timo sendo transplantado (imagem: Duke Health/UOL)
O transplante é visto como um avanço importante para a medicina. Claro, o paciente que passa por esse processo ainda vai precisar de acompanhamento médico por um tempo, o que não é nada comparado a ficar anos e anos na fila de espera por órgãos.
Mais uma prova legítima da importância da ciência nas nossas vidas. Uma relevância que não se limita apenas ao contexto de pandemia que vivemos, mas a toda nossa existência. Afinal, da infância até a velhice passamos por médicos pra cuidar do nosso bem mais precioso: a vida!
Easton já completou um ano com muitos motivos para comemorar. O transplante marca um recomeço, uma nova oportunidade de viver com saúde e dignidade.
Ele, obviamente, ainda é muito pequeno para entender isso. Mas, no futuro, poderá olhar para sua história e ver como, mesmo sem saber, foi importante para que mais vidas fossem salvas.
Que a ciência continue avançando e nos trazendo gratas surpresas como essas!
Fonte: UOL
Jornalista apaixonado por contar histórias. Paranaense radicado em São Paulo. Louco por viagens e experiências novas.






